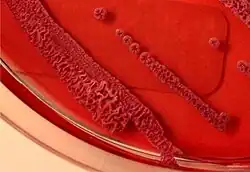

Ashdown's medium
Ashdown's medium is a selective culture medium for the isolation and characterisation of Burkholderia pseudomallei (the bacterium that causes melioidosis).
Ashdown's medium was first described by LR Ashdown in 1979.[1] It is used for the selective isolation of B. pseudomallei from clinical specimens taken from non-sterile sites (e.g., sputum)[2] as well as to produce the characteristic morphology of B. pseudomallei.[3]
The medium contains crystal violet and gentamicin as selective agents to suppress the growth of other bacteria. Colonies of B. pseudomallei also take up neutral red which is present in the medium, and this further helps to distinguish it from other bacteria. Gentamicin slightly inhibits the growth of B. pseudomallei and so specimens inoculated onto Ashdown's agar needs to be incubated for a minimum of 96 hours instead of 48 hours. The medium is also enriched with 4% glycerol, which is required by some strains of B. pseudomallei to grow. B. pseudomallei usually produces flat wrinkled purple colonies on Ashdown's agar.
Ashdown's medium has the advantage of being extremely cheap to produce: the cost of each plate is only US$0.04.[4]
References
- ^ Ashdown LR (1979). "An improved screening technique for isolation of Pseudomonas pseudomallei from clinical specimens". Pathology. 11 (2): 293–7. doi:10.3109/00313027909061954. PMID 460953.
- ^ Peacock SJ, Chieng G, Cheng AC, et al. (2005). "Comparison of Ashdown's medium, Burkholderia cepacia medium, and Burkholderia pseudomallei selective agar for clinical isolation of Burkholderia pseudomallei" (PDF). J Clin Microbiol. 43 (10): 5359–61. doi:10.1128/JCM.43.10.5359-5361.2005. PMC 1248505. PMID 16208018.
- ^ Chantratita N, Wuthiekanun V, Boonbumrung K, et al. (2007). "Biological relevance of colony morphology and phenotypic switching by Burkholderia pseudomallei". J Bacteriol. 189 (3): 807–17. doi:10.1128/JB.01258-06. PMC 1797308. PMID 17114252.
- ^ Phetsouvanh R, Phongmany S, Newton P, et al. (2001). "Melioidosis and Pandora's box in the Lao People's Democratic Republic". Clin Infect Dis. 32 (4): 653–4. doi:10.1086/318713. PMID 11181133.